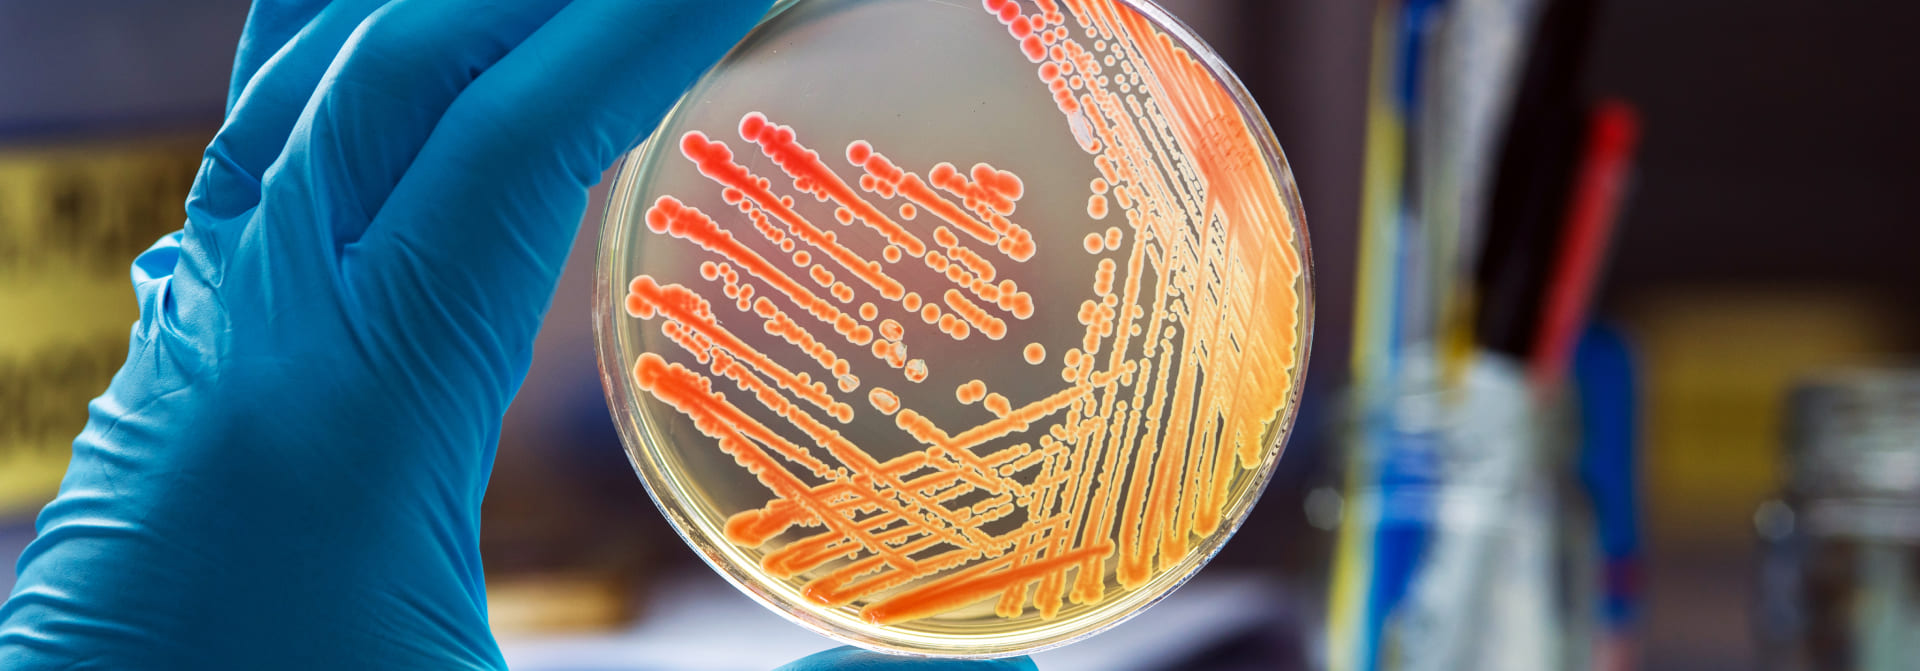

Медична лабораторія CSD LAB є ексклюзивним провайдером найпопулярнішого в світі неінвазивного пренатального тесту Panorama (Natera, USA). Це простий, безпечний та абсолютно безболісний метод пренатального тестування, ефективність якого підтверджена великою кількістю досліджень та публікацій.
Тест Panorama є неінвазивним пренатальним тестуванням (НІПТ) вагітних на найпоширеніші хромосомні та мікроделеційні синдроми плода. Тестування передбачає дослідження вільної фетальної ДНК у крові вагітної.
Перевагами тесту Panorama є можливість застосування та інформативність тесту з 9 тижнів вагітності (інші НІПТ - з 10 тижнів). Унікальна технологія SNP дозволяє відрізнити ДНК плода (плаценти) від ДНК вагітної, що дозволяє отримати більш точні результати, ніж у інших НІПТів.
Перелік станів, для яких валідовано тест Panorama, включає трисомії 21-ї (синдром Дауна), 13-ї (синдром Патау) та 18-ї (синдром Едвардса) пар хромосом, анеуплоїдії статевих хромосом (Синдром Тернера, синдром Клайнфельтера, синдром Якобса), найчастіші мікроделеційні синдроми - делеція 22q11.2 (ДіДжорджі), Прадер-Віллі, Ангельмана, котячого крику (5р-), делеції 1р36.
Panorama є генетичним тестом, тому для призначення тесту та пояснення результатів вагітна має звернутись до генетика або компетентного акушер-гінеколога.